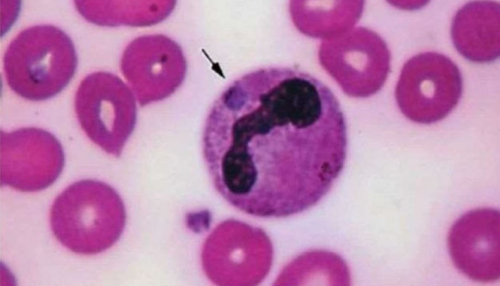

Anaplazmóza - ochorenie prenášané kliešťami

Anaplazmóza je ochorenie prenášané kliešťami vyskytujúce sa celosvetovo a v posledných rokoch ju zaznamenávame čoraz častejšie aj na Slovensku.
Pôvodcom ochorenia je mikroorganizmus Anaplasma phagocytophilum a Anplasma platys. Inkubačná doba je 1-2 týždne. Po nej môže nasledovať obdobie horúčkovitých stavov sprevádzaných zníženým počtom krvných doštičiek (trombocytov) v krvi. Väčšina psov zostáva zdravými.
Medzi príznaky patrí letargia a nechutenstvo. Tiež sa môže objaviť krívanie, zvracanie a hnačky. Medzi zriedkavé príznaky patrí kašeľ, krvácanie, nadmerné pitie a močenie. Anaplazmóza môže byť spúšťačom imunitne podmienených ochorení.
Pri podozrení na toto ochorenie je možné stanoviť protilátky v krvi. Dostupné sú testy ako Idexx 4Dx, ktoré nám povedia výsledok do 30 minút od odberu. V prípade pozitívneho výsledku je vhodné krv poslať do laboratória kde metódou PCR potvrdia prítomnosť mikroorganizmov v krvi.
Liečba spočíva v podávaní antibiotík ako doxycyklín alebo enrofloxacín počas 2-4 týždňov. Ide o veľmi účinné antibiotiká, ak sú psíkovia liečení v akútnej fáze ochorenia, prognóza je veľmi dobrá a stav sa zlepšuje už za 48 hodín. Dĺžku liečby je však potrebné zachovať. V prípade vážnych a chronických foriem ochorenia je prognóza vážna a psík je v ohrození života.
Preventívnym opatrením je podávanie antiparazitárnych prípravkov proti kliešťom v doporučených intervaloch výrobcami či už vo forme obojkov, pipiet alebo tabliet.
